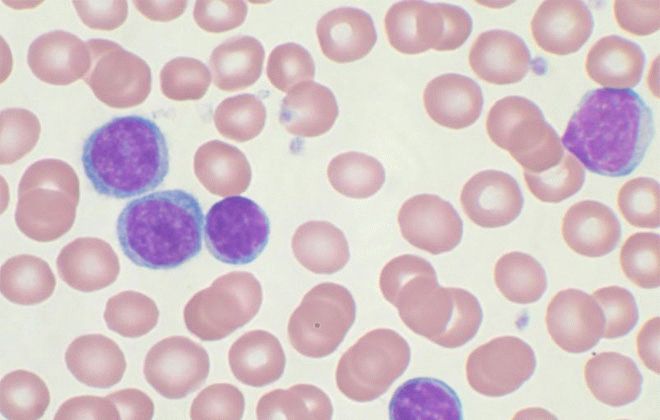

Какая статистика выживаемости у больных лимфобластным лейкозом
У больных с диагнозом острый лимфобластный лейкоз выживаемость зависит от своевременной постановки правильного диагноза. Позитивный настрой — одно из условий хорошего результата лечения.
Врачи отмечают, что острый лимфобластный лейкоз у детей является одной из наиболее распространенных форм рака в детском возрасте. Это заболевание характеризуется быстрым ростом незрелых лимфоцитов, что приводит к нарушению нормального кроветворения. Специалисты подчеркивают важность ранней диагностики, так как это значительно увеличивает шансы на успешное лечение. Современные методы терапии, включая химиотерапию и, в некоторых случаях, трансплантацию костного мозга, показывают высокую эффективность. Однако врачи также предупреждают о возможных долгосрочных последствиях лечения, таких как нарушения в развитии и функции органов. Поэтому комплексный подход к лечению и реабилитации детей с острым лимфобластным лейкозом является крайне важным. Врачи рекомендуют регулярные обследования и поддержку со стороны семьи для улучшения качества жизни маленьких пациентов.
https://youtube.com/watch?v=zWcND3hWmqU
Причины возникновения
Острый лимфобластный лейкоз — системное злокачественное заболевание. Вызывается неконтролируемым ростом лимфобластов. Точную причину развития болезни установить невозможно. Медики считают, что толчком для ее зарождения могут служить:
- неблагоприятный радиационный фон,
- генетическая предрасположенность,
- перенесенные вирусные инфекции,
- неправильное питание,
- контакт с вредными веществами,
- частые рентгенологические исследования.
Нет точных доказательств связи этих факторов с началом развития патологии, у большинства заболевших причина не определяется.
Симптомы и лечение
Потеря веса, слабость, быстрая утомляемость и головокружение могут быть симптомами злокачественной опухоли. Тошнота и рвота тоже свидетельствуют о начале болезни. Возможна высокая температура, кровотечения из носа, боли в животе с кровавой рвотой. Пораженные лимфоузлы хорошо прощупываются под кожей.
Основное лечение — химиотерапия. Ее действие направлено на снижение скорости деления злокачественных клеток и их полное истребление. При тяжелой форме одним из методов служит пересадка костного мозга. Лучевую терапию назначают, учитывая возможности иммунной системы.
Острый лимфобластный лейкоз у детей — это заболевание, которое вызывает много тревог как у родителей, так и у медицинских специалистов. Многие родители, столкнувшись с этой болезнью, отмечают, что первое время испытывают шок и не знают, как справиться с ситуацией. Важно, что поддержка со стороны врачей и психологов играет ключевую роль в процессе лечения. Родители часто делятся опытом, как они находят силы бороться с болезнью, и как важно сохранять позитивный настрой. В социальных сетях можно встретить множество групп, где семьи обмениваются советами и поддержкой. Также многие отмечают, что ранняя диагностика и современные методы лечения значительно повышают шансы на выздоровление. Несмотря на сложности, многие родители находят надежду в историях выздоровления и поддерживают друг друга в этом нелегком пути.
https://youtube.com/watch?v=kvzoTyy60Gk
Сколько живут
Патология из костного мозга быстро распространяется по всему организму, охватывая все органы и системы органов, проникая в центральную нервную систему. Заболевание развивается столь стремительно, что неоказание медицинской помощи вовремя влечет за собой летальный исход в 90% случаев. Малейшие признаки отклонений от нормального состояния должны стать поводом посетить доктора и пройти обследование.
Статистика показывает, что мутации клеток могут происходить даже при внутриутробном периоде. ОЛЛ чаще развивается в детском и подростковом возрасте. Мальчики в раннем детстве заболевают чаще, чем девочки. Из числа заболевших около 70% после лечения полностью выздоравливают. Причем важным фактором является возраст ребенка: дошкольники выживают чаще.
Дети и подростки благодаря активным процессам регенерации имеют максимальные шансы на выздоровление. Они быстрее и лучше реагируют на лечение и реабилитацию. У этой возрастной категории не так часто, как у людей среднего и преклонного возрастов, происходят рецидивы.
Лечение острого лимфобластного лейкоза у взрослых дается тяжело, иногда бывают осложнения, восстановление длительное. Хороший прогноз в среднем возрасте насчитывается у 60% от числа заболевших, 35-40% — показатели зрелого возраста (женщины живут дольше).
Решающим фактором, связанным с продолжительностью жизни, является состояние больного на протяжении нескольких лет после лечения. Медики выделяют 5-летний и 10-летний периоды. Если в течение 5 лет после всех терапевтических и хирургических мероприятий, включая период реабилитации, у пациента не произошел рецидив, вероятность вторичного лейкоза (возврата болезни) сильно снижается. После 10 лет возможным становится полное выздоровление.
Злокачественная опухоль при лейкозе развивается непредсказуемо, но грамотное лечение способно увеличить продолжительность жизни. На ее качестве сказывается своевременное выявление болезни, эффективность лекарственных средств, регулярность обследований после лечения. Если больной находится под постоянным наблюдением врача, следует всем рекомендациям, шансы на благоприятный исход возрастают.
Лечение лейкоза
Основным направлением лечения при лейкозах будет применение цитостатической терапии, направленной на уничтожение клеток 
Лечение лейкозов разделяется на определенные этапы. Среди них выделяют:
- создание ремиссии (индукцию ремиссии);
- поддержание достигнутой ремиссии;
- предупреждение поражения ЦНС (нейролейкемия);
- терапия в стадии ремиссии;
- проведение постиндукционного лечения.
Основными противоопухолевыми препаратами являются:
- Циклофосфамид,
- Ритуксимаб,
- Винкристин,
- Метотрексат,
- Меркаптопурин и т.д.
Справочно. Лечение проводится согласно специальным схемам. Препараты чередуются в зависимости от фазы и дня лечения. Вся терапия проводится под контролем анализов (включая регулярную пункцию костного мозга).
Цитостатические ср-ва комбинируют с глюкокортикостероидной терапией (дексаметазон, преднизолон).
Очень важно! Абсолютным противопоказанием к применению глюкокортикостероидов является инвазивная форма аспергиллеза (грибковая инфекция).
С целью предупреждения нейролейкемии, проводят облучение головы и назначение метотрексата эндолюмбальным способом (внутрь спинномозгового канала) или интратекально (под мозговые оболочки).
Дополнительно, по показаниям, проводится симптоматическая терапия (антибактериальная, противогрибковая, дезинтоксикационная), переливание крови и т.д.
Высокоэффективно проведение трансплантации костного мозга. После ее проведения практически не наблюдается рецидивов лейкозов. Однако существует риск гибели пациента, в результате отторжения трансплантанта и развития иммунодефицита.
Консультации онколога
Все лейкоциты в организме человека делятся на 2 типа — гранулоцитарные и агранулоцитарные (зернистые и незернистые), эти две группы, в свою очередь, подразделяются на эозинофилы, базофилы, нейтрофилы (гранулоцитарные), и лимфоциты (В- и Т-типа) и моноциты (агранулоцитарные).
В процессе созревания и развития (дифференцировки) все клетки проходят несколько этапов, первым из которых является бластный этап (лимфобласты). Из-за поражения костного мозга опухолью, лимфоциты не успевают достаточно развиться для того, чтобы полноценно исполнять свои защитные функции.
По большей части, при остром лимфобластном лейкозе поражаются В-лимфоциты (примерно в 85% случаев), отвечающие за образование антител в организме.
Различают два типа течения острого лимфобластного лейкоза ( ОЛЛ ): В-линейный и Т-линейный, в зависимости от типа клеток — лимфоидных предшественников.
Клинические симптомы острого лимфобластного лейкоза
Синдром интоксикации — слабость, лихорадка, недомогание, потеря веса. Лихорадка может быть связана и с наличием бактериальной, вирусной, грибковой или протозойной (реже) инфекцией, особенно у детей с нейтропенией (менее 1500 нейтрофилов в 1 мкл).
Гиперпластический синдром — увеличение всех групп периферических лимфоузлов. Инфильтрация печени и селезенки приводит к их увеличению, что может проявляться болями в животе.
При этом на рентгенограммах можно обнаружить характерные для лейкемической инфильтрации изменения, особенно в трубчатых костях, возле крупных суставов.
https://youtube.com/watch?v=Z1L5_Kd4fGw
Анемический синдром — бледность, слабость, тахикардия, кровоточивость слизистых полости рта, геморрагический синдром на коже, бледность. Слабость возникает в результате анемии и интоксикации.
Геморрагический синдром связан как с тромбоцитопенией, так и с внутрисосудистым тромбозом (особенно при гиперлейкоцитозе) и приводит к появлению петехий, экхимозов на коже и слизистых, кровоизлияниям, мелене, рвоте с кровью.
У мальчиков может обнаруживаться инициальное увеличение яичек ( 5-30% случаев первичного ОЛЛ). Это безболезненные, плотные, одно- или двусторонние инфильтраты. Особенно часто это бывает при гиперлейкоцитозе и Т-клеточном варианте ОЛЛ.
Могут появиться кровоизлияния в сетчатку глаза, отек зрительного нерва. При офтальмоскопии могут обнаруживаться лейкемические бляшки на глазном дне.
Из-за сильно сниженного иммунитета любое повреждение кожи является очагом инфекции, могут появиться паронихии, панариции, инфицированные укусы насекомых и следы инъекций.
Достаточно редкими осложнениями могут являться поражения почек в результате инфильтрации (клинические проявления могут и отсутствовать) и выпотной перикардит из-за нарушения лимфооттока между эндокардом и эпикардом.
Хронический лимфобластный лейкоз
Это онкологическое заболевание лимфатической ткани, при котором опухолевые лимфоциты накапливаются в периферической крови, костном мозге, лимфатических узлах, печени и селезенки.
В отличие от острых лейкозов, опухоль растет достаточно медленно, вследствие чего нарушения кроветворения развиваются лишь в поздних стадиях развития заболевания.
Чаще всего первым симптомом хронического лимфолейкоза является увеличение размеров лимфатических узлов. Вследствие сильного увеличения селезенки (до нескольких кг), возможно возникновение ощущения тяжести в животе.
Примерно в 25% случаев заболевание обнаруживают случайно при анализе крови, назначенном по другому поводу (диспансеризация, обследование по поводу негематологического заболевания).
Лейкозы. Классификация
- острые;
- хронические.
Острый лейкоз – это опухоль, субстратом (основой) которой выступают незрелые клетки – бласты.
Тип лейкоза, будет зависеть от того, какими бластами он представлен:
- острый миелобластный лейкоз,
- острый эритробластный лейкоз,
- острые монобластные лейкемии,
- острый лимфобластный лейкоз и т.д.
Если острое белокровие развивается из неидентифицируемых клеток, такой лейкоз крови называют недифференцируемым.
При хроническом лейкозе, подавляющее количество клеток опухоли будет представлено зрелыми клеточными элементами.
Острые лейкозы разделяют также на две большие группы: лимфобластные и нелимфобластные.
В группе острых нелимфобластных лейкозов выделяют семь гистологических типов:
- М0 – недифференцированные лейкозы;
- М1 – миелобластные без цитохимических признаков созревания клеток;
- М2 – миелобластный лейкоз крови с созреванием клеток;
- М3 – промиелоцитарный (базофильный и эозинофильный);
- М4 – миеломонобластные;
- М5 – монобластные;
- М6 – эритроцитарные;
- М7 – мегакариобластные лейкозы.
Острый лимфобластный лейкоз разделяют на три гистологических типа:
- Л1 – микролимфоцитарный (встречается в 25% случаев);
- Л2 – типичный лимфобластный лейкоз (встречаетя в 70% случаев, такой тип лейкоза более характерен для взрослых пациентов);
- Л3 – макролимфобластный (наиболее редкая форма).
Также, острый лимфобластный лейкоз классифицируют по типу преобладающих в опухоли лимфоцитарных клеток:
- Т – лимфобластные лейкозы;
- В – лимфобластные лейкозы;
- Ноль – лимфобластные (ни Т, ни В-) лейкозы.
Хронические лейкозы разделяют на:
- миелопролиферативные опухоли (хронические миелолейкозы, эритремии, хронические макрофагальные лейкозы и т.д.);
- димфопролиферативные опухоли (хронические лимфолейкозы);
- парапротеинемические гемобластозы (миеломную болезнь, болезни легких и тяжелых цепей и т.д.);
- нейролейкемические гемобластозы (лимфоцитомы, лимфосаркомы).
Диагностика и лечение острого лимфобластного лейкоза у взрослых
Говоря «острый», врачи подразумевают быстрое прогрессирование недуга или переход на другие органы или же ткани. В случае когда лечение вообще не наблюдается, то выживаемость равна нулю
Обратите внимание, что заболевание затрагивает незрелые лимфоидные клетки
Стоит сказать, что многие виды лейкоза лечатся достаточно успешно. Главное – только вовремя начать терапию. Что же касается статистики, то наблюдается недуг у одного пациента на 750 человек. Чаще всего, он поражает мужчин и детей. Таким образом, следует проводить систематические обследования, дабы вовремя выявить влияние и назначить терапевтический процесс.
Основные причины
Точные данные пока выявлены не были. Все же медицине известны основные причины возникновения. Рассмотрим их более подробно:
Так как достоверных сведений не имеется, лучше всего вести здоровый образ жизни, а также избегать негативного влияния извне.
Основные симптомы
Если верить практике, то основными признаками являются потеря аппетита, снижается масса тела, а также постоянная усталость. В некоторых случаях наблюдаются лихорадки или же ночная потливость. Это далеко не все:
- Недостаток нормальных клеток крови. В этом случае возникают частые кровотечения, одышка, постоянные инфекции.
- Так как клетки часто накапливаются во внутренних органах, например, в печени или селезенке, то они увеличиваются в размерах. Как результат, живот отекает.
- Увеличение лимфатических узлов также говорит о наличии заболевания. В этом случае поражаются основные ткани.
- Боль в костях и суставах. Патологические клетки также могут накапливаться в суставах или же костях человека.
- Увеличенная в размерах вилочковая железа.
Как проходит лечение
Заметили первые признаки у себя или ребенка? Сразу же направляйтесь к специалисту. Именно он назначит все необходимые анализы по программе. Да, лимфобластный лейкоз достаточно тяжело выявить на ранних стадиях, однако ранняя тревога даст нужные результаты.
Как и всегда, используются химические препараты, которые убивают раковые клетки в крови, снижая распространение патологии.
Возможные прогнозы
Стоит сказать, что некоторые исследования в этой области дали понять, какие особенности человека помогают легче перенести недуг:
- Во-первых, это возраст. Чем моложе пациент, тем шансы на выздоровления будут гораздо больше.
- Низкое число лейкоцитов при постановке диагноза повышает шансы на положительные результаты лечения.
- Выживаемость при Т-клеточном лейкозе гораздо выше, чем при В-клеточном.
- Полная ремиссия – первый успех. У тех пациентов, которые достигли этого на шестой неделе, выздоровление проходит быстрее.
Также имеет значение, насколько же хорошо влияют препараты. Достаточно часто врачи используют термин «ремиссия». Это временные рамки, когда симптомы болезни не наблюдаются. Что же касается ремиссии лейкоза, то показания должны быть в норме, например, уровень лимфобластных клеток не превышает 5%, а количество лейкоцитов ближе к норме.
Минимальная остаточная болезнь – это период, когда обычные исследования не дают положительных результатов. Зато патологии подтверждаются при цитометрии. Стоит сказать, что пациенты, услышавшие данный термин, должны готовиться к рецидиву. Прогнозы не являются достаточно положительными.
Как бы там ни было, а своевременное обращение к профессионалам решает многое. Практика показывает, что современные отечественные больницы достаточно ограничены в своих методах, соответственно, и лечение окажется неэффективным.
Таким образом, следует уделять внимание только настоящим специалистам с богатым опытом работы и качественным оборудованием. Именно они поставят вам точный диагноз и назначат необходимые препараты
Этиопатогенез
Точные причины возникновения ОЛЛ неизвестны. Предполагают, что, как и в случае других злокачественных заболеваний, болезнь развивается в результате неблагоприятного сочетания воздействия окружающей среды, наследственной предрасположенности и шанса. Изучение этиологии ОЛЛ усложняется разнообразием подтипов болезни, каждый из которых может иметь свои причины.
Возникновение злокачественного клона
Считают, что в случае детского В-ОЛЛ предлейкозный клон возникает в организме ребёнка ещё в ходе внутриутробного развития. При В-ОЛЛ, ассоциированном с мутацией гена MLL, злокачественное перерождение B-клетки, по всей видимости, завершается до рождения. Это подтверждается тем, что если он возникает у одного из монозиготных близнецов с общей или монохориональной плацентой, то возникает и у второго с вероятностью практически 100 % и проявляется вскоре после рождения. Пик заболеваемости В-ОЛЛ с другими цитогенетическими характеристиками приходится на более поздний возраст — 2—5 лет. Эти виды лейкоза развиваются у обоих близнецов только в 10—15 % случаев. Это может говорить о том, что, хотя предлейкозный клон возникает во время внутриутробного развития, для его окончательной трансформации нужны дополнительные события.
Возможные причины и факторы риска
В качестве возможных причин ОЛЛ рассматривают:
- ионизирующую радиацию — ионизирующая радиация была выявлена как причина ОЛЛ и других видов лейкоза при изучении последствий атомных бомбардировок Японии. Повышенная частота развития ОЛЛ была обнаружена у людей, работавших с радиографическим оборудованием до установления современного уровня безопасности. Люди, прошедшие курс радиотерапии, имеют повышенный риск развития так называемых вторичных лейкозов, в том числе и ОЛЛ. Рентгеновская пельвиметрия во время беременности немного увеличивает риск развития ОЛЛ у ребёнка, при этом риск растёт пропорционально числу процедур. Некоторые исследователи предполагают, что естественная радиация и космическое излучение могут быть причинами ОЛЛ, но эта точка зрения является спорной;
- инфекции — возбудитель детского ОЛЛ до сих пор не был обнаружен. Существует несколько гипотез на этот счёт, но они сходятся в том, что развитие лейкоза является результатом аномального иммунного ответа на присутствие инфекционного агента. По гипотезе Кинлена, причиной детского ОЛЛ является неизвестный возбудитель, скорее всего вирус, к которому у большинства детей развивается естественный иммунитет, однако у небольшой части особенно чувствительных детей этот возбудитель вызывает лейкоз. По гипотезе Гривса, причиной детского ОЛЛ может быть множество неспецифических возбудителей (например, вирусы гриппа), которые вызывают спонтанные мутации в B-клетках детей, имевших мало контактов с патогенами на первом—втором годах жизни (например, не посещавших ясли);
- генетическую предрасположенность — мутации, вызывающие ОЛЛ с высокой пенетрантностью, пока не обнаружены. Однако широкомасштабные исследования генома заболевших выявили, что некоторые аллельные варианты генов IKZF1, ARID5B, CEBPE и CDKN2A ассоциированы с повышенным риском развития ОЛЛ. Такие аллели имеют аддитивный эффект. Продукты перечисленных генов вовлечены в дифференцировку и пролиферацию кровяных клеток. Также риск развития ОЛЛ резко повышен у больных синдромом Дауна — примерно в 40 раз у детей в возрасте до четырёх лет.
Заключение
ОЛЛ — заболевание, наиболее характерное для детского возраста, но встретиться может и у взрослых. Этиология заболевания точно до сих пор не определена, в инициацию и развитие вносят вклад ряд факторов: генетические мутации, воздействие физических и химических факторов окружающей среды.
Различные морфологические варианты лейкозов могут характеризоваться специфическими хромосомными перестройками, что важно для диагностики и лечения. Что касается лечения — современные технологии позволяют проводить щадящую лучевую терапию, также проводится химиотерапия и трансплантация костного мозга
Прогноз зависит от иммунологического фенотипа лейкозных клеток, возраста, пола пациента, своевременности диагностики, наличия или отсутствия осложнений и поражения органов и систем.
Стоит заметить, что у детей заболевание протекает легче, и есть большая вероятность достижения длительной клинической и клинико-гематологической ремиссии.
Мария Вишнякова, Лечебное дело 16 статей на сайте
В данное время продолжаю работать в должности медицинской сестры гематологического отделения ГБУЗ АО «Архангельская областная клиническая больница» и обучаться в СГМУ. Сферой моих профессиональных интересов являются патологическая анатомия и онкология.
Вопрос-ответ
Что такое острый лимфобластный лейкоз и как он проявляется у детей?
Острый лимфобластный лейкоз (ОЛЛ) — это рак крови, который возникает из-за аномального роста лимфобластов, незрелых клеток крови. У детей он может проявляться различными симптомами, такими как усталость, бледность, частые инфекции, синяки или кровотечения, а также увеличение лимфатических узлов и печени.
Как диагностируется острый лимфобластный лейкоз у детей?
Диагностика ОЛЛ включает в себя анализ крови, который показывает уровень различных клеток крови, а также костномозговую биопсию для подтверждения наличия аномальных лимфобластов. Дополнительно могут проводиться молекулярно-генетические исследования для определения подтипа лейкоза и выбора наиболее эффективного лечения.
Каковы основные методы лечения острого лимфобластного лейкоза у детей?
Основными методами лечения ОЛЛ являются химиотерапия, которая направлена на уничтожение раковых клеток, и, в некоторых случаях, трансплантация костного мозга. Лечение может быть длительным и требует регулярного мониторинга состояния пациента, чтобы оценить эффективность терапии и предотвратить рецидивы.
Советы
СОВЕТ №1
Обратите внимание на ранние симптомы. Острый лимфобластный лейкоз может проявляться различными симптомами, такими как усталость, бледность, частые инфекции, синяки и кровотечения. Если вы заметили у вашего ребенка подобные признаки, не откладывайте визит к врачу.
СОВЕТ №2
Изучите информацию о заболевании. Понимание острого лимфобластного лейкоза, его причинах, методах диагностики и лечения поможет вам лучше поддерживать вашего ребенка и принимать обоснованные решения в процессе лечения.
СОВЕТ №3
Создайте поддерживающую среду. Психологическая поддержка очень важна для детей, проходящих лечение. Убедитесь, что ваш ребенок чувствует себя любимым и защищенным, общайтесь с ним о его чувствах и переживаниях.
СОВЕТ №4
Сотрудничайте с медицинской командой. Регулярно общайтесь с врачами и медсестрами, задавайте вопросы и уточняйте все моменты, касающиеся лечения. Это поможет вам быть в курсе состояния здоровья вашего ребенка и принимать активное участие в его лечении.